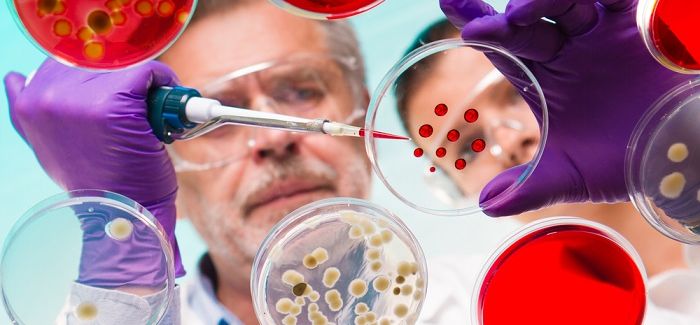

Most Read By Author
For international students who want to become part of the solution to providing bette…
Learn more about civil engineering careers in Infrastructure with this student profile.
When Liu Chang says he’s fascinated by plants, he doesn’t mean he’s a keen gardener...
To find a job in the automotive industry after grad school, you will need to possess industry s…
What made one graduate biology student decide on Sweden?
被分享最多的文章 by Author

How to Tell if a Career in C…

为什么说应该到中国学习环境政策?

How One University Is Aiming…

What It’s Like to be an Inno…

Political Education in Italy…

开启计算机科学生涯的7种准备方法
Related Articles by Author

从事旅游数字营销的3个理由

开启计算机科学生涯的7种准备方法

出国留学可以为你的未来带来奇迹的七种方式

出国留学:如何在文化冲击中生存

5 STEM Degrees With Amazing…